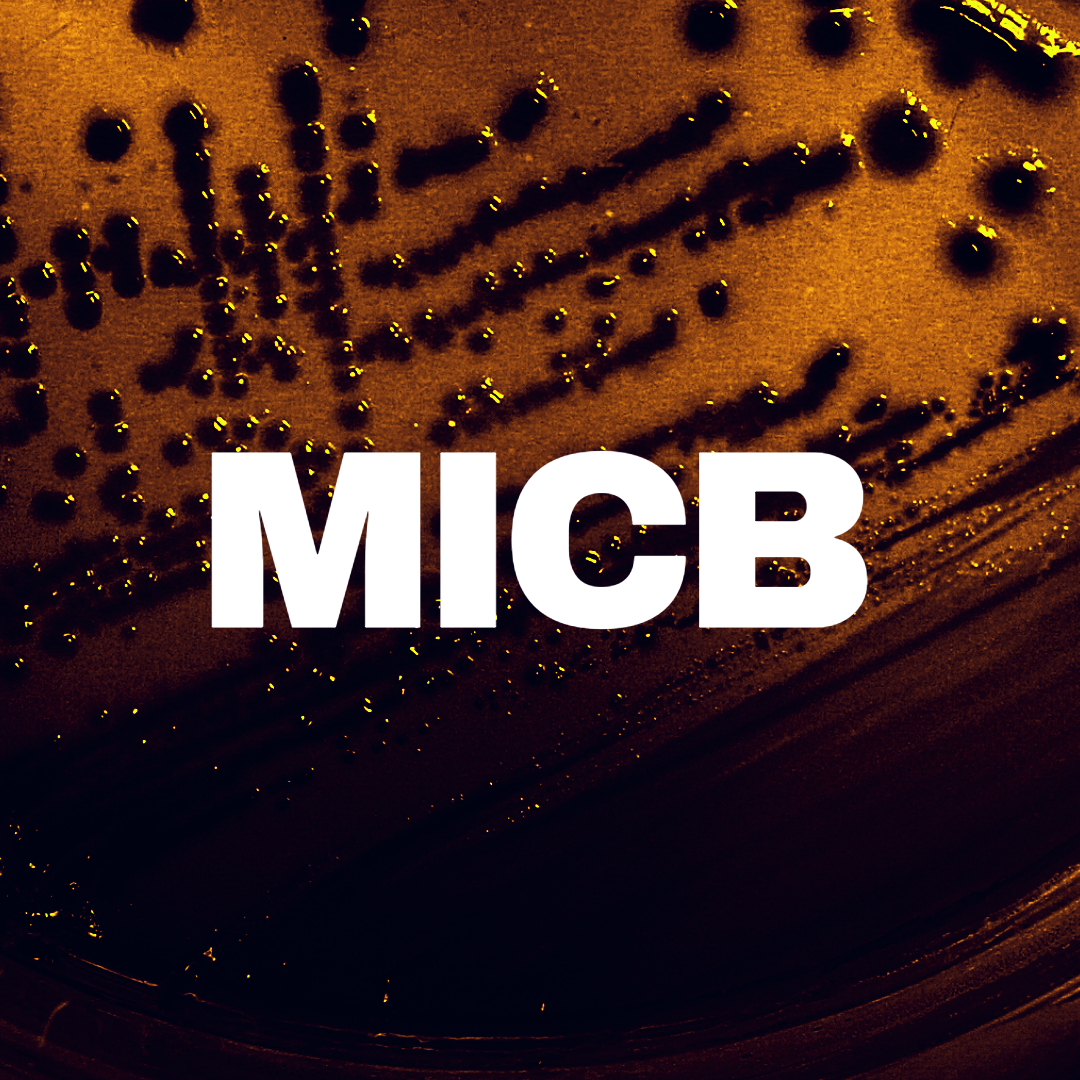
Bold white text that reads "MICB" on a dark orange background.

Students can pursue the program’s General Biology (GENB) track or specialize in a different area of study.
All Biological Sciences majors, regardless of specialization, must fulfill the same General Education (GenEd), basic program, and supporting course requirements.
The courses that become required for the major’s advanced program vary by specialization. All students—regardless of specialization—will earn a Maryland degree (BS) that reads Biological Sciences upon completing all of the necessary degree requirements.
-
Current students who are looking to change their specialization can submit a request form through TerpEngage at go.umd.edu/majorchange.
If a major change request is submitted during the schedule adjustment period, then it may be reviewed and updated in the same semester.
Submissions after the schedule adjustment period will become effective in the subsequent semester. A major change is not complete until the CMNS Office of Student Services has approved it.
Prospective students or those enrolled in the College of Letters & Sciences who are interested in declaring Biological Sciences: go to bsci.umd.edu/declare for next steps.
The Model Grad Plan (MGP)
—illustrates coursework semester-by-semester, and is a model for responsible grad planning under each specialization.
Degree sheets illustrate the several advanced course options that will satisfy degree requirements under each specialization in Biological Sciences. The advanced program is on page two of each degree sheet.
Start building a grad plan for Biological Sciences:
General Biology (GENB)
General Biology broadly trains students in processes from the subcellular to ecosystem level. The specialization prepares students for graduate study, medicine, secondary school teaching, science writing, professional schools, business related careers, and basic or applied research.
-
-
The sample job titles below exemplify positions that Biological Sciences majors are qualified for upon graduation. This is not an exhaustive list, but a starting point for exploration.
See the full GENB Career Guide for more information.
Research Associate/Assistant
Project Manager
Medical Scribe
Medical/Dental Assistant
Physical Therapy Aide
Science Health Policy Analyst
Lab Technician/Manager
Bioinformatics Analyst
Clinical Assistant
Analyst
Clinical Data Specialist
Genetic Counseling Assistant
Science Teacher
Care Coordinator
Cell Biology & Genetics (CEBG)
This specialization focuses on the molecular and cellular processes that support all life. It prepares students for graduate study and careers in medicine, dentistry, forensic science, genetic counseling, or work in biotechnology.
-
-
The sample job titles below exemplify positions that Cell Biology & Genetics majors are qualified for upon graduation. This is not an exhaustive list, but a starting point for exploration.
See the full CEBG Career Guide for more information.
Scribe
Implementation Consultant
Research Assistant/Technician
Post-baccalaureate Researcher
Laboratory Assistant/Technician
Care Coordinator
Genetic Counseling Assistant
Repository Technician
Associate
Manufacturing Associate
Bioinformatics Analyst
Science Health Policy Analyst
Client Navigator
Clinical Allergy Specialist
Ecology & Evolution (ECEV)
This specialization focuses on the study of organisms interacting with their environment in more complex biological systems. It prepares students for graduate study, basic and applied research, and careers in conservation, environmental biology, veterinary medicine, employment in zoos, or work in science policy.
-
-
The sample job titles below exemplify positions that Ecology & Evolution majors are qualified for upon graduation. This is not an exhaustive list, but a starting point for exploration.
See the full ECEV Career Guide for more information.
Research Associate
Lab Technician
Logistics Administrator
Lab Manager
Science Teacher
Sea Turtle Technician
Scientist
Ecologist
Environmentalist
Physician Assistant
Field Educator/Outdoor Educator
Veterinary Hospital and Conservation Programs Coordinator
Science Policy Fellow
Microbiology (MICB)
This specialization focuses on microorganisms including their role in the environment, their relationship to other organisms in health & disease, and their use in biotechnology. This specialization prepares students for graduate study, careers in medicine, public health, forensics, biotechnology, and pharmaceuticals.
-
-
The sample job titles below exemplify positions that Microbiology majors are qualified for upon graduation. This is not an exhaustive list, but a starting point for exploration.
See the full MICB Career Guide for more information.
Laboratory Assistant/Technician
Laboratory Manager
Clinical Procedure Assistant
ORISE Fellow
Research Associate/Technician
Peer Educator
Project Manager
Clinical Research Trial Recruiter
Biologist
Research Lab Assistant
Biological Laboratory Technician
Scientist
Pediatric Therapy Aide
Physiology & Neurobiology (PHNB)
This specialization integrates multiple scales of biological organization to better understand how organisms function. It prepares students for graduate study, medicine, dentistry, allied health fields, and basic or applied research.
-
-
The sample job titles below exemplify positions that Physiology & Neurobiology majors are qualified for upon graduation. This is not an exhaustive list, but a starting point for exploration.
See the full PHNB Career Guide for more information.
Research Associate/Assistant
Project Manager
Medical Scribe
Medical/Dental Assistant
Physical Therapy Aide
Research Fellow
Lab Technician/Manager
Technology Recruiter
Clinical Assistant
Business Technology Analyst
Clinical Data Specialist
Genomic Analyst
Management Consulting Analyst
Pathology Lab Technician
Individualized Studies (BIVS)
This specialization allows students to combine the rigors of a life sciences degree with interdisciplinary studies. BIVS students can integrate studies in biology with fields such as mathematics, physics, linguistics, or psychology. BIVS is reserved for students with truly interdisciplinary interests, and requires a written plan of study approved by the Assistant Dean of Undergraduate Academic Programs.
Contact Dr. Sara Lombardi, Director of Biological Sciences | email: saral@umd.edu